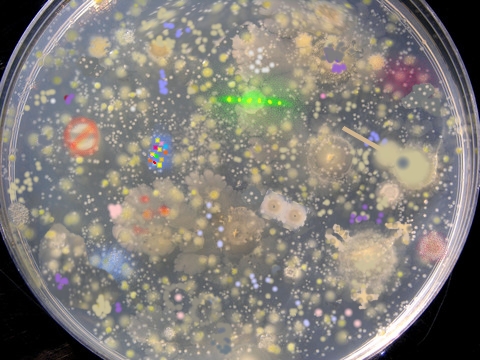
culture change

| Any resemblance? |  |
 |
 |
 |
| See the effects? |  |
 |
 |
 |
| See the fallout? |  |
 |
 |
 |
| See the results? |  |
 |
 |
 |
| See the mess? |  |
 |


|
 |
| Any resemblance? |  |
 |
 |
 |
| See the effects? |  |
 |
 |
 |
| See the fallout? |  |
 |
 |
 |
| See the results? |  |
 |
 |
 |
| See the mess? |  |
|


|
 |
| Will these work? |  |
 |
 |
 |
| What about these? |  |
 |
 |
 |
| And try these? |  |
 |
 |
 |
| Stupid Ideas? |  |
 |
 |
 |
| Having doubts? |  |
 |
 |
 |
| Covidictor Just Desserts | Vax Mandator gets his. |
Mask Dictator gets his. |
Economy Closer gets his. |
Virus Scoffer gets his. |
 |
 |
 |
 |
 Too many leaders are overstepping the Constitutional bounds of their powers.
Too many leaders are overstepping the Constitutional bounds of their powers.
- Cuomo is the worst. He acts like a dictator.
- Again, Cuomo is the worst.
- Democrats act like they planned the whole thing to win the election next fall.
|
|

|
|
THE ECONOMY 
|
|

|
|
| Stop the virus! |  |
 |
 |
 |
| Pan-da-mic |  |
 |
 |
 |
| Overkill government |  |
 |
 |
 |
| Some deterrents |  |
 |
 |
 |
| Other Stuff |  |
 |
 |
 |
| Moore deterrents |  |
 |
 |
 |
| Other wackies |  |
 |
 |
 |
| Wear a mask? |  |
 |
 |
 |
| Oh the wackiest |  |
 |
 |
 |
| Kill and disrupt |
 |
 |
 |
 |
| Discharge or scatter |
 |
 |
 |
 |
| Santa Claus | Sanitizer Claus | Sanity Clause | Sanitary Claus | Sanctity Claus | Insane19 Claus |
 |
 |
 |
 |
 |
 |
| Notice these: | Hidin' Biden Masker Dictator |
Master Plandictor Harris |
Covid 19 economic devastation |
Is this a virus? |
 |
 |
 |
 |
|
| Mask Disguises: | Fauci Mask |
China Virus Mask |
Covir 19 mask |
I Camn't Bbbreathe (gasp). |
 |
 |
 |
 |
| Life is a Dirty Trick* | Someone added to a Mercedes logo for a peace car. |
What government restrictions did to people's lives. |
When a golf ball drive hits a snow-covered hill. |
The "don't" economy. |
 |
 |
 |
 |
|
| More Weird Things! | FDR told Popeye to eat spinach due to misplaced decimal point. |
What government overkill does to people's lives. |
Cast of idiot tyrants in charge: |
There goes everything out the window and very far away. |
 |
 |




|
 |
|
| Mower Weird Things! | Hire a really good DJ. No party. Just the DJ. |
There goes the election messed up by mail voting tricks. |
Are you upside down? Flip your home. |
Why socialism is mouse manure: |
 |
 |
 |
MICE DIE IN MOUSETRAPS BECAUSE THEY DON'T KNOW WHY THE CHEESE IS FREE
|
|
| Weared Things! | Sound the alarm! The dictators are attacking! |
This text is on a label on a Parcheesi game I have: |
I hate meetings anyway. |
Government went blooey!
I hate meetings anyway. |
 |
CAUTION:
SMALL PARTS INCLUDED FOR CAUSING DAMAGE TO CHILDREN |
 |
 |
|
| Weird Thinks! | I bought some radios. This warning was in the instructions. |
What the destroyed economy did to people's lives. |
I hate meetings anyway. |
Toe Crusher will stop this mess. |
|
Warning:
Do not lose this radio in closet while installing dead batteries |
 |
WORK CAREFULLY
ACCIDENTS CAUSE MEETINGS |
 |
|
| Snorts Spews | Bascovidball |
Football rule changes: |
COVID-19 Twists the Season Stats |
COVID-19 Twists and Wins the Tournament |
 |
 - NO BLOCK
- NO BLOCK- NO TOUCH - NO TACKLE - 2 FACE MASKS - SANITIZE THE BALL BEFORE EACH PASS |
 |
 |
|
| Sign in | Signs posted on all of the GPS satellites. |
Footcovidball |
New WWF regulations for 2020-2021. |
Clean up after yourself. |
|
NOTICE:
DUE TO COVID-19, PLANET EARTH IS NOW CLOSED DETOUR TO NEXT PLANET |
 |
RULE CHANGE:
CONTESTANTS MUST STAY 6 FEET APART AND SANITIZE ALL THROWN ITEMS |
PLEASE SWEEP UP ALL STRAY VIRUSES YOU LEFT ON THE
PREMISES
|
|
| Notice these: | Signs in Sweden (translated). |
Wow! I didn't know that. |
Chokies??? |
A vision of reopening the economy. |
|
Notice to Virus
Please do not infect us. We are not fighting you. |
THEY SAY THE EARLY BIRD GETS THE WORM
BUT THE SECOND MOUSE GETS THE CHEESE |
 |
 |
* Without God.